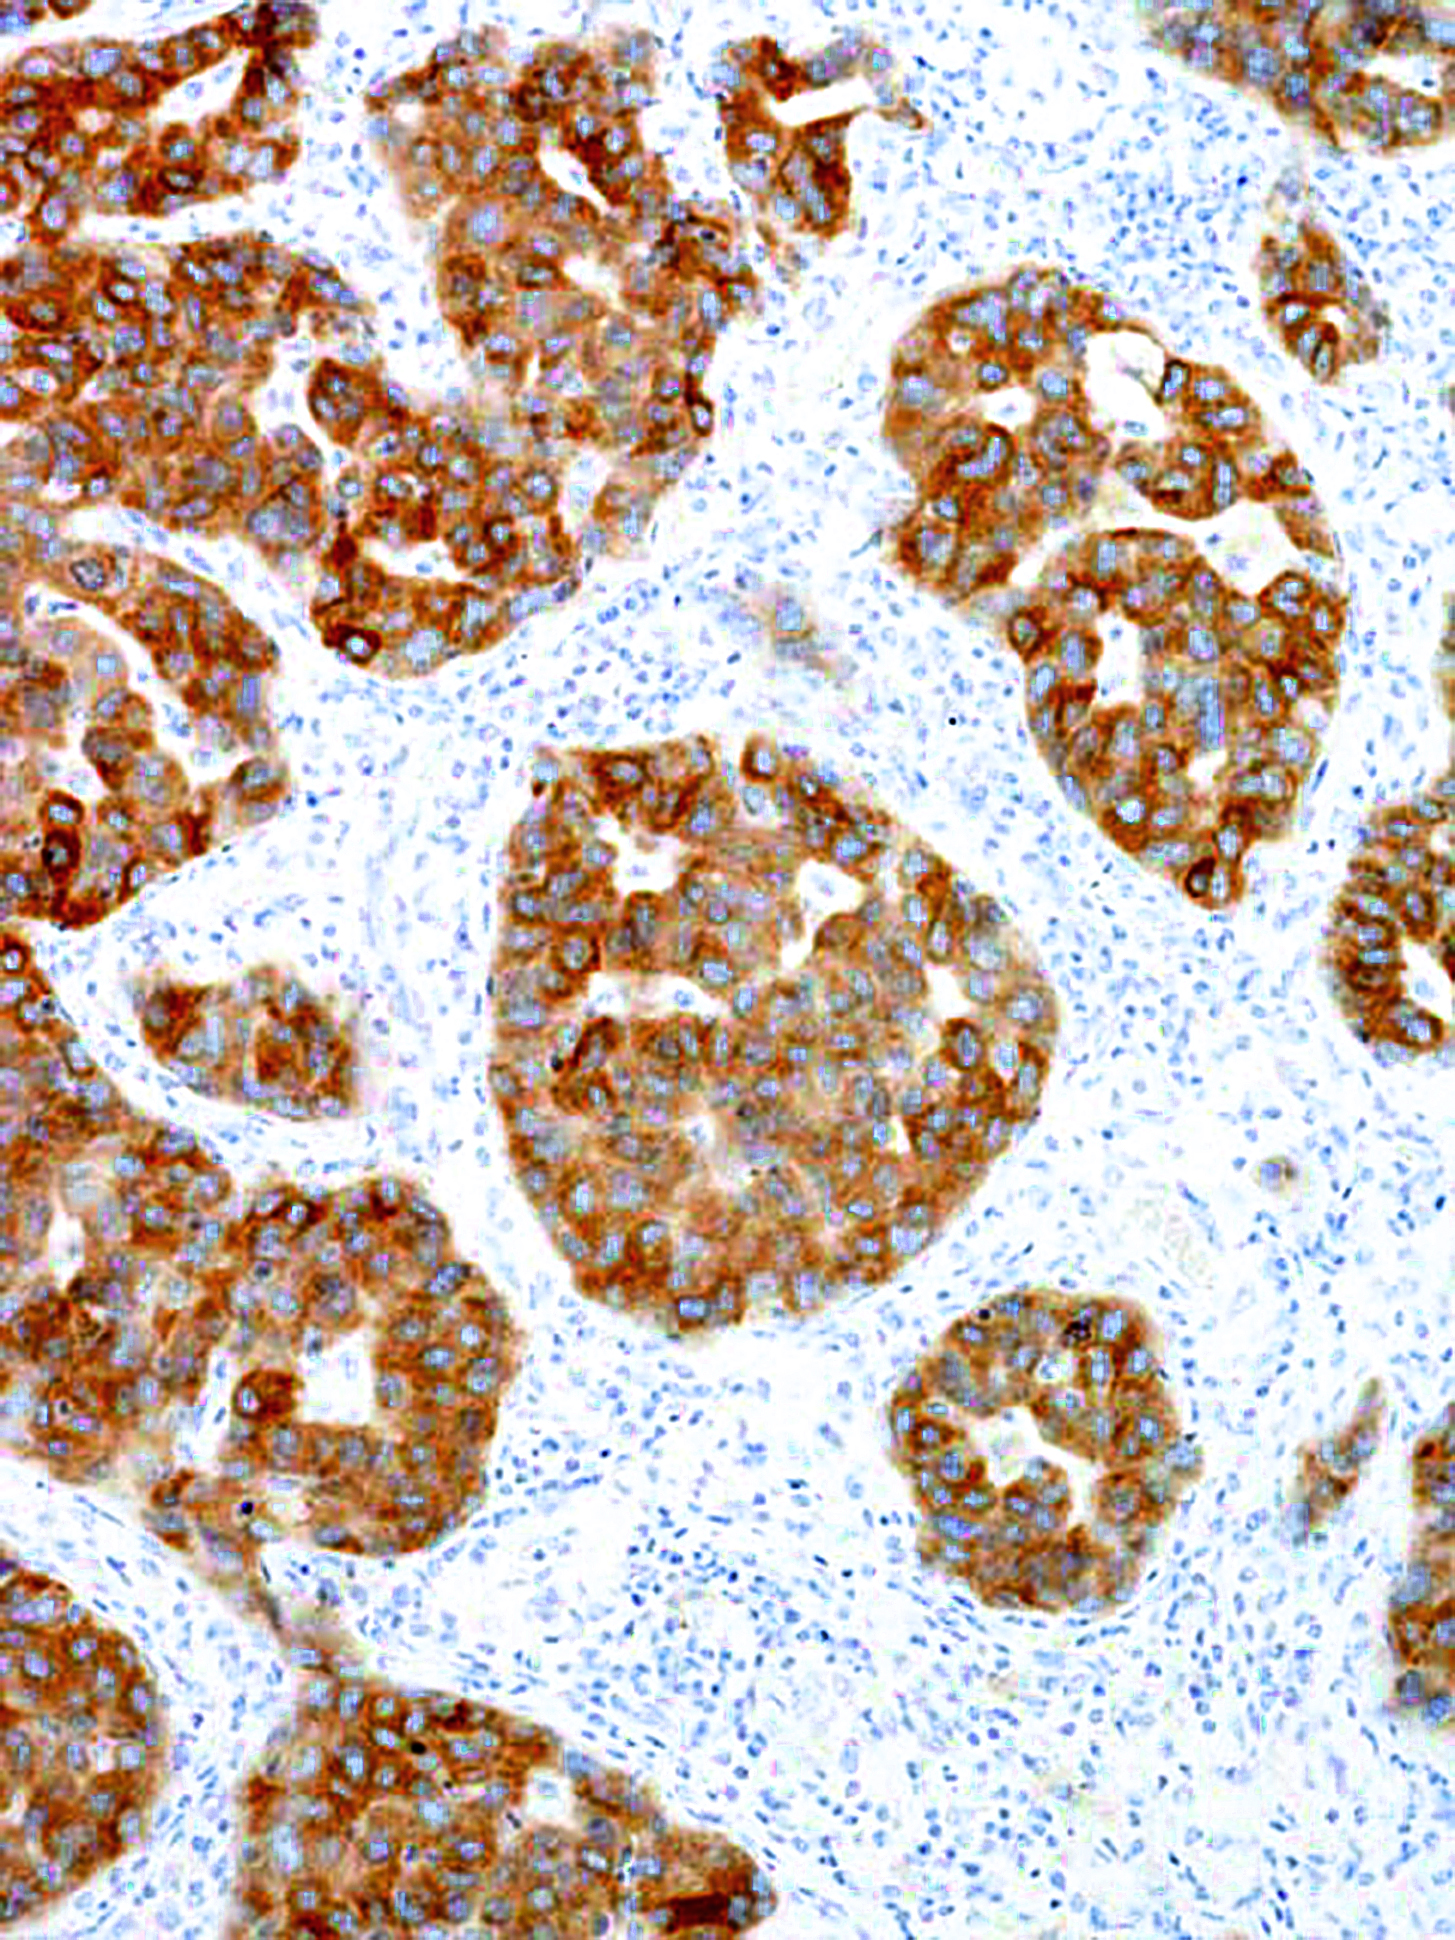

[Genomeme] ALK
CAT. NO. IHC509-100
CLONE:
IHC509
ISOTYPE:
IgG2b
HOST SPECIES:
Mouse
CLONALITY:
Monoclonal
POSITIVE CONTROL:
Anaplastic Large Cell Lymphoma
DILUTION RANGE:
INTENDED USE/REG. STATUS:
RUO
Anaplastic Lymphoma Kinase (ALK) is a receptor tyrosine kinase which plays a role in brain and nervous system development. ALK is typically expressed at low levels in regions of the developing central and peripheral nervous system, such as the neonatal brain and spinal cord. The most common genetic alterations of this gene are chromosomal translocations, which result in multiple ALK fusion proteins that are involved in tumourigenesis, as in the case of anaplastic large cell lymphoma (ALCL), lung adenocarcinoma, and inflammatory myofibroblastic tumours. Aberrant ALK expression is also found in other tumours such as familial neuroblastoma, non-small cell lung carcinoma (NSCLC), and brain cancers.
휴바이오랩(Hubiolab)
Hubiolab(휴바이오랩)
컨설팅 원하는 제품 군을 찾지만 시간이 맞지 않거나, 소요되는 제품이 맞지 않으면, 적절한 제품을 찾아서 최대한 진행을 도와 드립니다. Get Started
www.hubiolab.com
hubiolab@gmail.com
010-9468-7169
'Genomeme' 카테고리의 다른 글
| [Genomeme] Actin, Smooth Muscle (0) | 2023.05.22 |
|---|---|
| [Genomeme] N-cadherin (0) | 2023.05.18 |
| [Genomeme] EZH2 (0) | 2022.12.01 |
| [Genomeme] Arginase-1 (0) | 2022.09.28 |
| [Genomeme] HER2/neu (0) | 2022.08.18 |